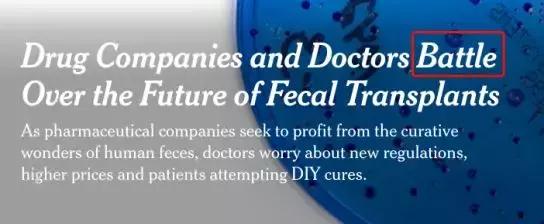
科学家是如何治疗帕金森病的,治疗帕金森病前沿科技成果

//前言//
在中国,
捐血不仅能帮助他人,
而且还能在家人遇险时
优先得到血库支持,
某些大学还会为捐血的学生加学分;
可在澳洲,
各大医院鼓励民众捐的物品中,
竟是如下图所示的人体排泄物…


1、抢“屎”背后
看到这个标题,很多读者可能丈二和尚摸不着脑袋,直接是一头雾水。活了二十多年了,每天都“生产”却一直认为无用的东西,还能捐献?还被澳洲美国等发达国家的医生哄抢?

这也太奇葩了吧?是不是小编在吓唬人啊?
(图片来源:The New York Times)
是的,你没看错!医疗公司和医生真的都在疯抢人们的便便。
小编也没有吓唬你,这项捐献风已经席卷澳洲和美国了。
近日在马萨诸塞州剑桥市(CAMBRIDGE, Mass),医疗保健领域爆发了一场新的战争,几亿美元和数千人的生命处于纠葛之中。这场让制药公司与医生针锋相对的斗争,正围绕着最让人意想不到的物质展开:人类排泄物。
看到这里大家肯定会觉得,哎呀,多大点事嘛,还值得学者们争来争去的?大家一人扔一坨给他们不就得了?

事情没有大家想的那么简单…
原来,有一种叫做粪便微生物群移植(F.M.T.)的革命性的治疗方法,在治疗艰难梭菌(Clostridioides difficile)(一种每年侵袭高达50万人次的美国人,并导致3万人死亡的细菌感染)方面被证明是非常有效的。
上述的病症听起来离我们还是很遥远,且听小编继续说重点,这项技术还有更广泛的运用:
科学家们看到了这一技术治疗糖尿病和癌症的潜力!
难道大家吃屎就能治好糖尿病吗!原来学友哥早早就发现了这一秘诀?

别慌,患者是不用做出吃屎这种行为艺术的,医生们疗法的操作方式是将健康捐献者的粪便转移到患病患者的肠道中,恢复被抗生素杀死的肠道微生物群落。
真正起到作用的就是这些生物群落,对于人体健康的帮助极大!

(图片来源:The New York Times)
早在2013年,食品药品监督管理局(The F.D.A.)就宣布了一项决定草案,将该疗法作为一种新药物进行管理,一些研究人员表示: 这项新技术被认为对大脑健康发育和免疫功能至关重要。

(图片来源:The New York Times)
权威机构的发言使得这项技术的重要性变得不言而喻,而各大机构的疯抢正是因为这项技术带来的巨大利益。
《纽约时报》的卡亚娜·西姆恰克(Kayana Szymczak)也表示“人们有理由担心粪便的捐献问题,因为对于许多病人来说,粪便移植是生死存亡的问题。”
粪便移植基金会的创始人Catherine Duff说:“令人担忧的是,企业的贪婪会使真正需要治疗患者们承受高昂的费用。”
2、 大便真的有用吗?
上文提到的都是权威机构的说明,可是大家并没有看到实际例子,所以很多人可能还是心存疑虑:“总不能你说屎有用我就信你吧!“

事实上,还真的有人因为粪便得益:

(图片来源:The New York Times)
上图是现年66岁的退休卡车司机斯蒂芬·肖(Stephen Shaw)先生,他去年的大部分时间里都被拴在马桶上与糖尿病作斗争,与此同时,他还患有肠道疾病:在住院期间,他因反复使用抗生素治疗导致了一系列感染。
“我不能去任何地方,因为担心自己会心情爆炸,”他回忆起多次弄脏自己的事。“我的生活被毁了。”

(图片来源:The New York Times)
12月下旬,凯利医生(Dr. Colleen Kelly)通过结肠镜给该患者进行了大便移植,几个小时后,患者开始感觉好多了。
直到圣诞节,他的排便完全恢复了正常。
他被治愈后说:“从来没想过噩梦会这么简单就结束,只希望大型制药公司将来不要让像我这样的人们负担不起治疗费用。”
受这次移植成功的启发,科学家们正在努力开发一系列疾病的疗法其中包括肥胖、孤独症、溃疡性结肠炎、阿尔茨海默病和帕金森病。
投资者也注意到了这一点,他们正在向初创企业注资数千万美元,以寻求下一个微生物群研究突破。
3、澳洲捐屎现状
原来,是我们孤陋寡闻了,人们觉得不起眼甚至有些嫌弃的大便,也可以有奇效的。

忍不住夸赞一下现代医学的伟大,在患者们快要绝望时,拯救他们于水火!

(图片来源:悉尼的消化疾病中心官网)
其实早在去年的六月,悉尼的消化疾病中心(CDD)就报道了这样一则消息:肠胃科医生汤姆·博洛迪教授(Tom Borody)成为澳洲第一位引进粪便移植的学者,当时很多人都表示无法相信有这种事。

(图片来源:悉尼的消化疾病中心官网)
该学者现在是悉尼大学的兼职教授,他早在1988年进行了第一次移植手术,当时,他在进行了艰难的思想斗争后决定尝试一下,结果成功了。尽管有人反对,他还是坚持了下去,并且他在治疗艰难梭菌(上文第一段有该菌种解释)方面取得了显著的成果!现在国内外的其他人都在复制这一成果。
教授自在悉尼中西部建立了消化疾病中心以来,进行了14000多个粪便移植。大约8年前,他在澳大利亚建立了第一家“布朗银行(brown bank)”,以储存富含优良细菌的健康粪便样本。

(图片来源:Daily Telgraph)
根据报道,他有一批精选的捐献者。
前方高能请注意!捐献并不是免费的,所有捐献者每次捐赠都会获得50澳币的报酬,报酬最高的一年达到了13,000澳币!
这也太过分了吧!辛辛苦苦的干了一年还没有人家拉粑粑挣得多!

不过捐粑粑也是有难度的,不仅需要调整自己的饮食,服用特定的益生菌,还要住得离诊所近!
小编哭晕在洗手间,可能付完房租每天省下时间都只能拉屎了…还是老老实实干活吧。

最后,
捐赠有风险,
大家还是要努力干自己的事业呀!